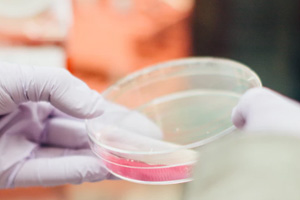

Intelligent Medicine
Intelligent Medicine is the new comprehensive, high-tech and interdisciplinary discipline that studies the structure, function, physiology process and pathological process of organism especially human body at multiple levels with the modern AI technique and engineering principles and methods, then propose the method to diagnosis and prevention the disease. The discipline is a knowledge-intensive, technology-intensive, wide aperture and wide coverage engineering field that combine the science, engineering and medicine. The research directions include: biomedical electronics, biomedical signal processing, biomedical photonics, neural engineering and rehabilitation engineering, medical physics, medical imaging and image processing, scientific instruments based on AI techniques. Coverage areas include: the interdisciplinary science and technology aimed at disease prevention, diagnosis, treatment and rehabilitation, the development and application of medical devices and other biomedical engineering products.